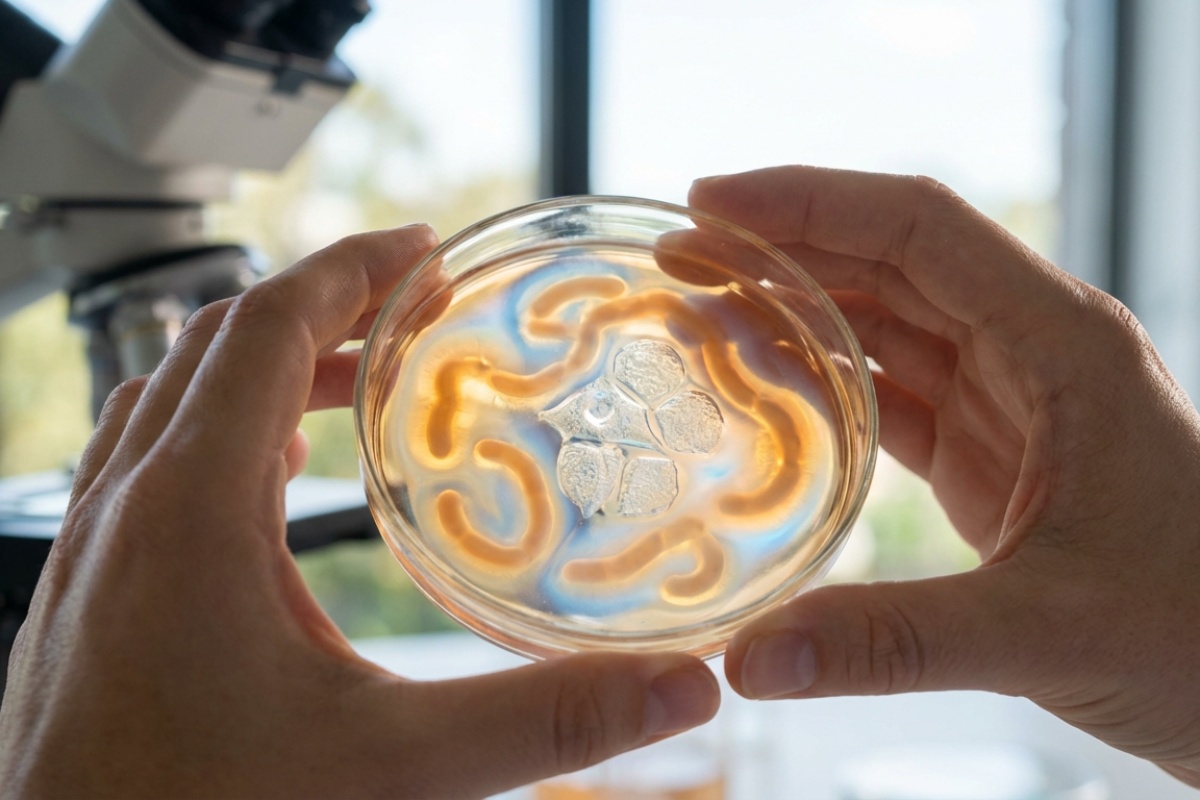
Fermentirani kupus koji djeluje bolje od probiotika: zašto kimchi nazivaju hranom dugovječnosti detail 2

U svijetu moderne prehrane i zdravlja, probiotici su postali nezaobilazna tema. Police ljekarni preplavljene su bočicama i kapsulama koje obećavaju bolju probavu i jači imunitet. Međutim, stručnjaci sve češće usmjeravaju pogled prema istoku, točnije prema Koreji, gdje se tajna zdravlja krije u jednostavnoj, ali moćnoj posudi s fermentiranim povrćem. Riječ je o kimchiju, tradicionalnom jelu koje nije samo prilog, već pravi eliksir života.
Kimchi nije samo trend; to je kulturna baština koja postoji tisućama godina. No, zašto ga znanstvenici i nutricionisti stavljaju na pijedestal, ponekad čak i iznad skupih dodataka prehrani? Odgovor leži u složenom procesu fermentacije i sinergiji sastojaka koji čine ovo jelo pravom bombom za zdravlje.
Što čini kimchi superhranom?
Osnova kimchija je kineski kupus, ali ono što ga čini posebnim je proces lakto-fermentacije. Tijekom tog procesa, prirodni šećeri iz povrća pretvaraju se u mliječnu kiselinu uz pomoć bakterija Lactobacillus. Upravo su te bakterije ključne za zdravlje našeg probavnog sustava.

Za razliku od običnog kiselog kupusa, kimchi je obogaćen nizom funkcionalnih sastojaka:
- Češnjak i đumbir: Poznati po svojim protuupalnim i antimikrobnim svojstvima.
- Chili papričice (Gochugaru): Sadrže kapsaicin koji ubrzava metabolizam i potiče cirkulaciju.
- Mladi luk i rotkvica: Dodaju vlakna i specifične fitonutrijente.
Ova kombinacija stvara okruženje u kojem se razvijaju raznoliki sojevi dobrih bakterija, često u većem broju i raznolikosti nego što ih možemo pronaći u standardnim probiotičkim kapsulama.
Zašto je fermentirana hrana bolja od tableta?
Mnogi se pitaju zašto bi trebali jesti začinjeni kupus umjesto da jednostavno popiju tabletu. Ključna riječ ovdje je bioraspoloživost. Hranjive tvari iz cjelovite hrane naše tijelo lakše prepoznaje i apsorbira. Kada konzumirate kimchi, ne unosite samo izolirane bakterije, već i prebiotike (vlakna) koja tim bakterijama služe kao hrana.
Sinteza vitamina tijekom fermentacije je još jedan fascinantan proces. Količina vitamina C i vitamina B skupine drastično se povećava tijekom zrenja kimchija. Osim toga, žive kulture u kimchiju su otpornije na želučanu kiselinu jer dolaze u „zaštićenom” matriksu hrane, što znači da veći broj njih stiže živ do vaših crijeva.
Kimchi i dugovječnost: Što kaže znanost?
Naziv „hrana dugovječnosti” nije samo marketinški trik. Istraživanja su pokazala da redovita konzumacija fermentirane hrane može smanjiti rizik od raznih kroničnih bolesti koje su povezane sa starenjem. Zdrav crijevni mikrobiom izravno je povezan s:
- Jačim imunološkim sustavom: Većina naših imunoloških stanica nalazi se u crijevima.
- Mentalnim zdravljem: Kroz os crijeva-mozak, zdrava flora može smanjiti simptome anksioznosti i depresije.
- Smanjenjem upala: Kronična upala je tihi ubojica i uzrok mnogih bolesti, a antioksidansi u kimchiju pomažu u borbi protiv nje.
Korejci, koji kimchi jedu uz gotovo svaki obrok, često se ističu kao nacija s niskom stopom pretilosti i određenih vrsta karcinoma, što se dijelom pripisuje njihovoj prehrani bogatoj fermentiranim namirnicama.
Kako uključiti kimchi u svakodnevnu prehranu?
Ako niste navikli na pikantne okuse, počnite polako. Kimchi je vrlo svestran. Iako se tradicionalno jede kao prilog uz rižu, možete ga dodati u juhe, variva, ili čak u sendviče (popularni kimchi tost). Međutim, važno je napomenuti jednu stvar: kako biste sačuvali probiotike, nemojte ga kuhati na visokim temperaturama predugo. Najbolje ga je dodati u toplo jelo na samom kraju ili ga jesti sirovog.

Važno je napomenuti da, zbog udjela soli i začina, osobe s visokim krvnim tlakom ili osjetljivim želucem trebaju biti umjerene. No za većinu ljudi, mala porcija kimchija dnevno može učiniti čuda za energiju i probavu.
Zaključno, kimchi je savršen primjer kako drevna mudrost može nadmašiti moderna farmaceutska rješenja. Vraćanjem prirodnim, fermentiranim namirnicama, ne samo da obogaćujemo svoj jelovnik uzbudljivim okusima, već činimo dugoročnu investiciju u svoje zdravlje i vitalnost.
